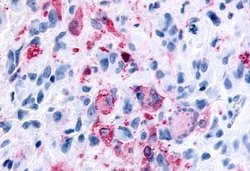
Invitrogen GPR43 Polyclonal Antibody 25 &mu;g | Buy Online | Invitrogen&trade; | Fisher Scientific

missing translation for 'onlineSavingsMsg'
Learn More
Learn More
Invitrogen™ GPR43 Polyclonal Antibody
Description
PA1-20419 detects G Protein-Coupled Receptor GPR43 in human samples.
G protein-coupled receptors (GPCRs, or GPRs) contain 7 transmembrane domains and transduce extracellular signals through heterotrimeric G proteins. GPCR GPR43 is a member of this family (subfamily carboxylic acid). It expression has been reported primarily in immune cells including monocytes and neutrophils. An EST has been isolated from a human pancreatic library.

Specifications
Specifications
| Antigen | GPR43 |
| Applications | Immunohistochemistry (Paraffin) |
| Classification | Polyclonal |
| Concentration | 1 mg/mL |
| Conjugate | Unconjugated |
| Formulation | PBS with 0.1% sodium azide |
| Gene | FFAR2 |
| Gene Accession No. | O15552 |
| Gene Alias | fatty acid receptor 2; FFA2; FFA2R; FFAR2; free fatty acid activated receptor 2; free fatty acid receptor 2; G protein-coupled receptor 43; GPCR43; Gpr43; G-protein coupled receptor 43; leukocyte-specific STAT-induced GPCR; Lssig |
| Gene Symbols | FFAR2 |
| Show More |
Product Title
By clicking Submit, you acknowledge that you may be contacted by Fisher Scientific in regards to the feedback you have provided in this form. We will not share your information for any other purposes. All contact information provided shall also be maintained in accordance with our Privacy Policy.
Spot an opportunity for improvement?